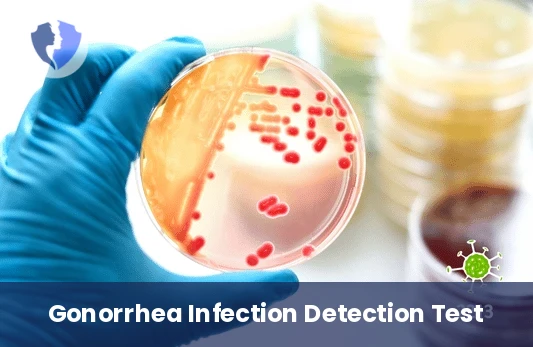
Rapid Gonorrhea Smear Test - Neisseria Gonorrhoeae Smear

Service Details
Rapid Gonorrhea Smear Test - Neisseria Gonorrhoeae Smear
A direct microscopic examination of discharge samples using special staining techniques (Gram stain) to detect Neisseria gonorrhoeae bacteria. The bacteria appear as Gram-negative diplococci inside white blood cells.